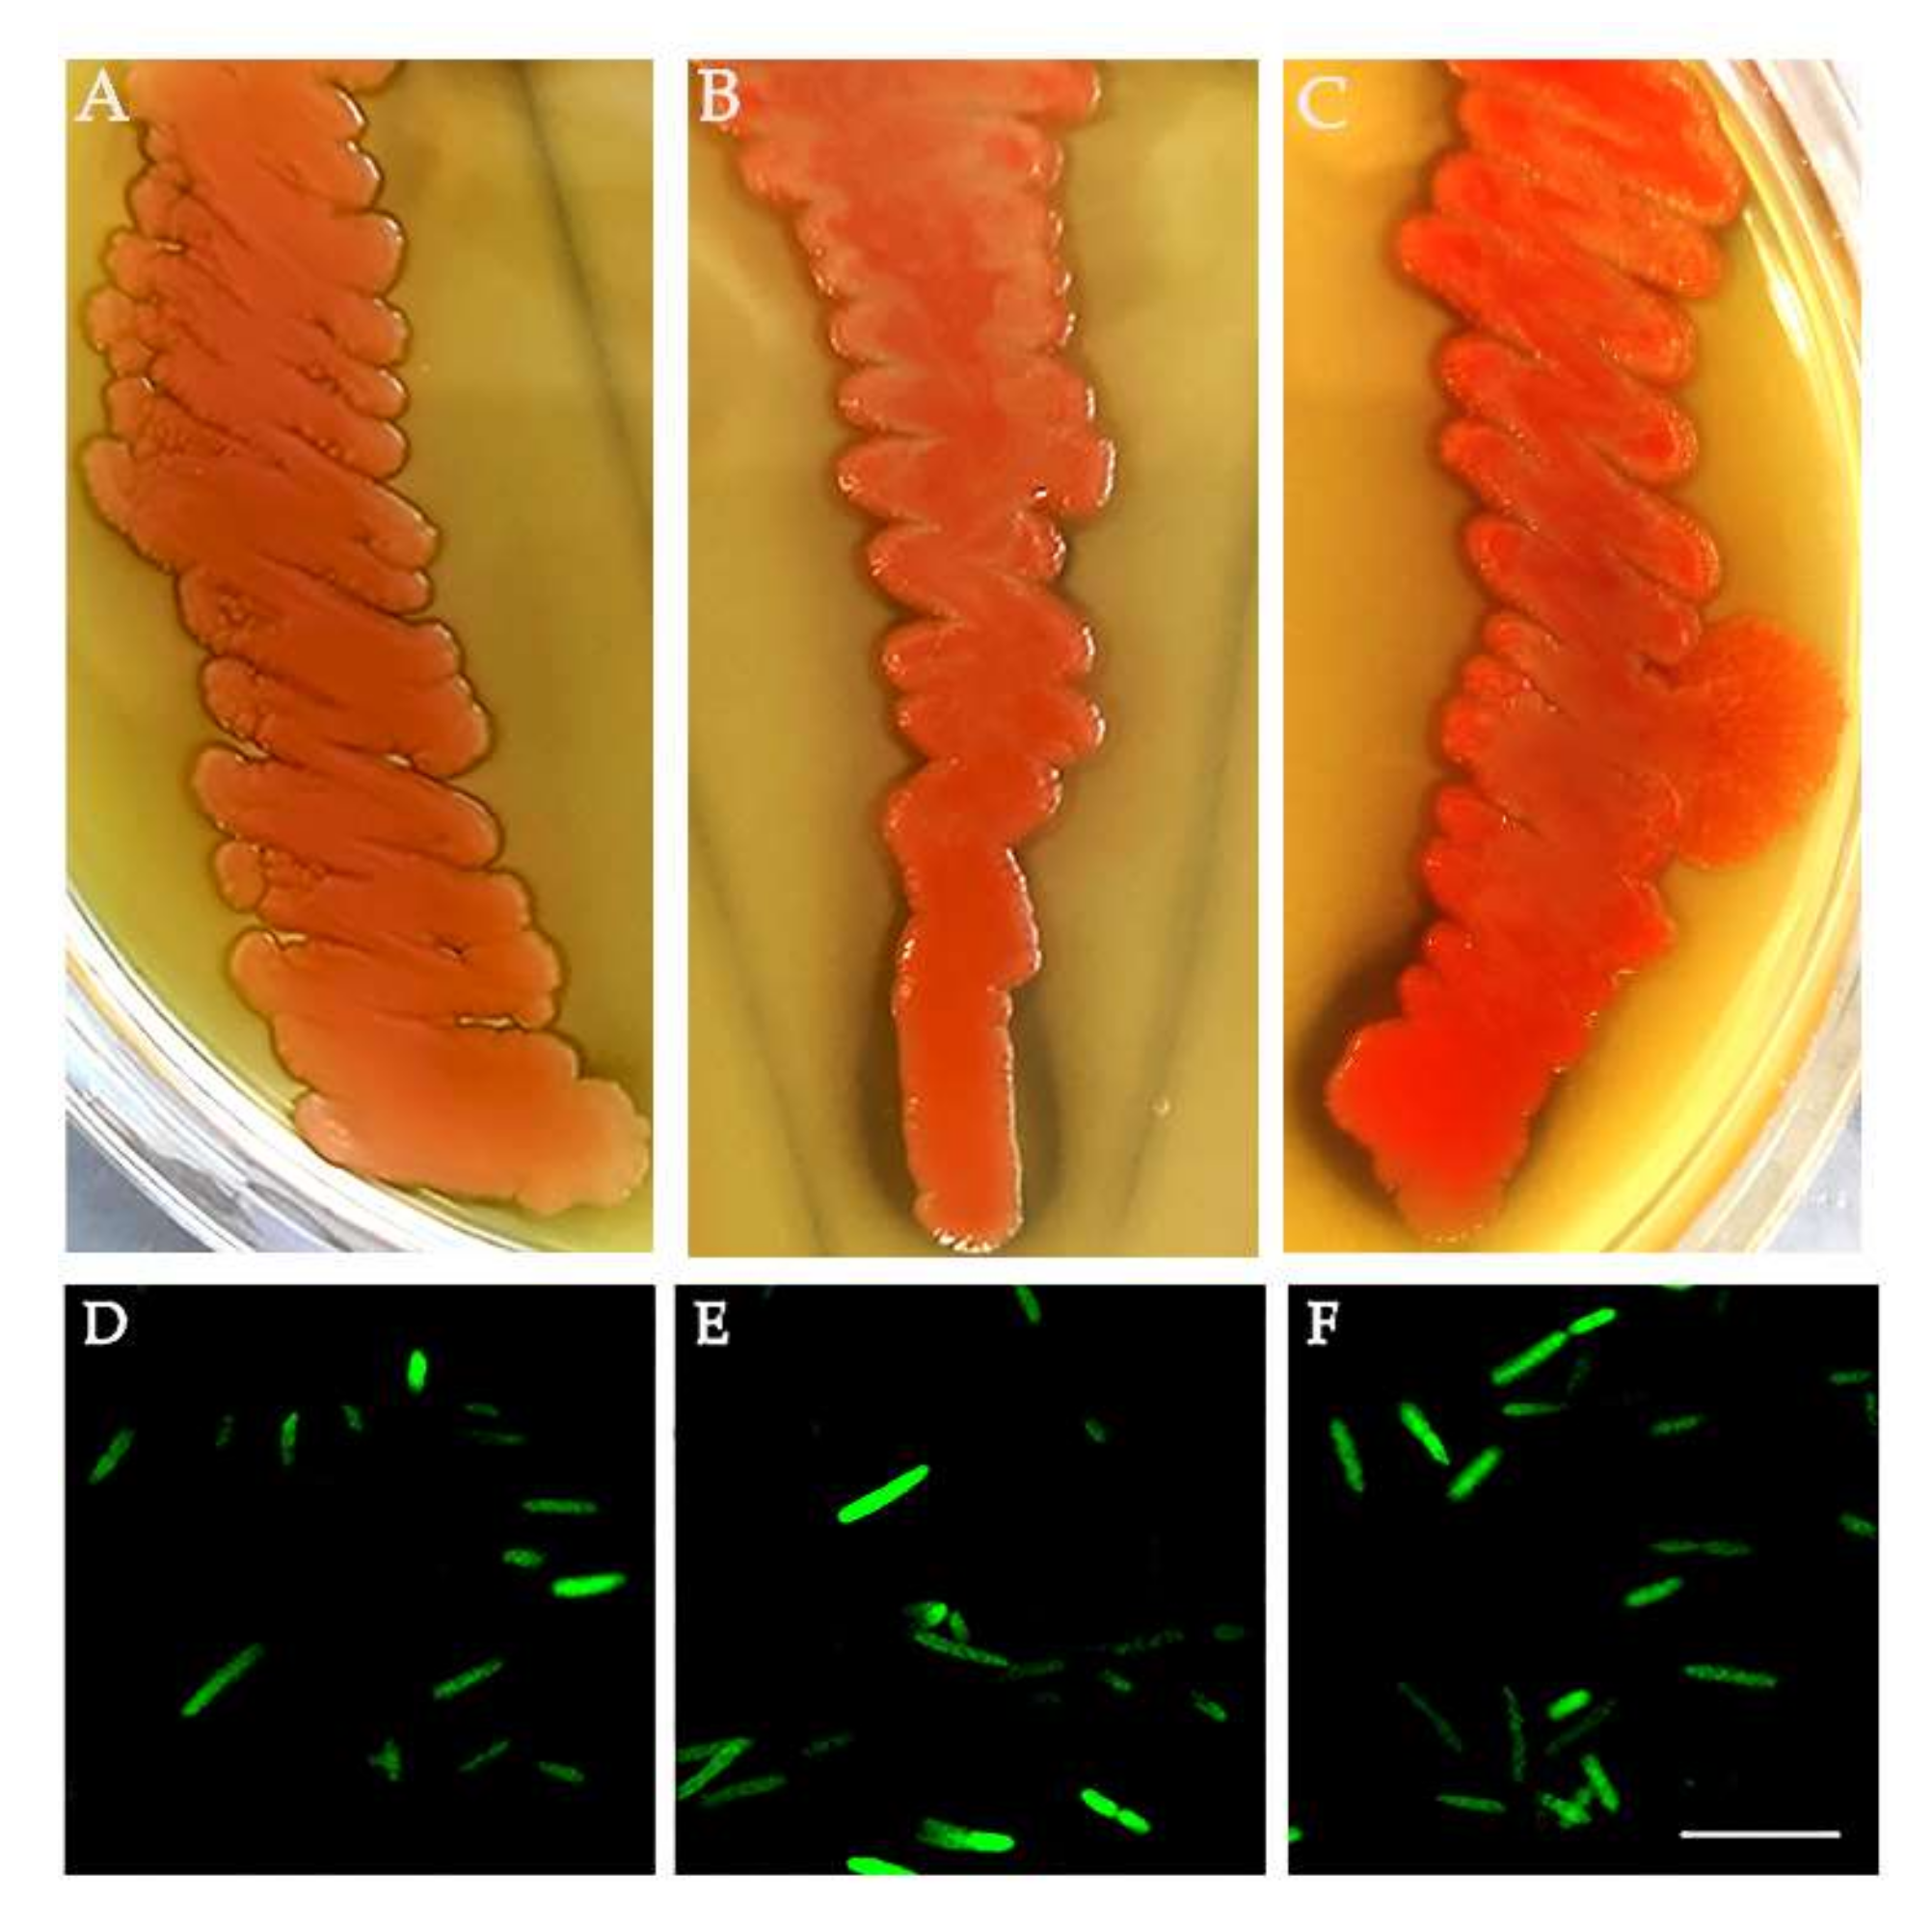
Insects 13 00474 g003

Bacterial Symbionts in Ceratitis capitata
Abstract
:Simple Summary
Abstract
1. Introduction
2. Materials and Methods
2.1. Ceratitis capitata Rearing
2.2. DNA Extraction
2.3. 16S rRNA Profiling
2.4. Molecular Detection of Asaia
2.5. Asaia Isolation from C. capitata Adults
2.6. Asaia sp. Transformation
2.7. Medfly Recolonization by Asaia Expressing Green Fluorescent Protein (Gfp)
2.8. Isolation of Bacteria from the ISPRA Population
2.9. Antagonistic Assay
3. Results
3.1. 16S rRNA Profiling
3.2. Detection, Isolation and Transformation of Asaia from C. capitata Populations
3.3. Medfly Recolonization Using Asaia Strain Expressing Green Fluorescent Protein (Gfp)
3.4. Bacteria Isolation from the ISPRA Population and Activity Test
4. Discussion
5. Conclusions
Supplementary Materials
Author Contributions
Funding
Institutional Review Board Statement
Informed Consent Statement
Data Availability Statement
Conflicts of Interest
References
- White, I.M.; Elson-Harris, M.M. Fruit Flies of Economic Significance: Their Identification and Bionomics; CABI Publishing: Wallingford, UK, 1992. [Google Scholar]
- Malacrida, A.R.; Gomulski, L.M.; Bonizzoni, M.; Bertin, S.; Gasperi, G.; Guglielmino, C.R. Globalization and fruitfly invasion and expansion: The medfly paradigm. Genetica 2007, 131, 1–9. [Google Scholar] [CrossRef] [PubMed]
- Plá, I.; García de Oteyza, J.; Tur, C.; Martínez, M.; Laurín, M.C.; Alonso, E.; Martínez, M.; Martín, Á.; Sanchis, R.; Navarro, M.C.; et al. Sterile Insect Technique Programme against Mediterranean Fruit Fly in the Valencian Community (Spain). Insects 2021, 12, 415. [Google Scholar] [CrossRef] [PubMed]
- Vreysen, M.J.B.; Abd-Alla, A.M.M.; Bourtzis, K.; Bouyer, J.; Caceres, C.; de Beer, C.; Oliveira Carvalho, D.; Maiga, H.; Mamai, W.; Nikolouli, K.; et al. The Insect Pest Control Laboratory of the Joint FAO/IAEA Programme: Ten Years (2010–2020) of Research and Development, Achievements and Challenges in Support of the Sterile Insect Technique. Insects 2021, 12, 346. [Google Scholar] [CrossRef] [PubMed]
- Utarini, A.; Indriani, C.; Ahmad, R.A.; Tantowijoyo, W.; Arguni, E.; Ansari, M.R.; Supriyati, E.; Wardana, D.S.; Meitika, Y.; Ernesia, I.; et al. Efficacy of Wolbachia-Infected Mosquito Deployments for the Control of Dengue. N. Engl. J. Med. 2021, 384, 2177–2186. [Google Scholar] [CrossRef]
- Li, H.; Wei, Y.; Yuan, G.; Guan, R. Insight into maize gene expression profiles responses to symbiotic bacteria derived from Helicoverpa armigera and Ostrinia furnacalis. Arch. Microbiol. 2021, 204, 56. [Google Scholar] [CrossRef]
- Polenogova, O.V.; Noskov, Y.A.; Artemchenko, A.S.; Zhangissina, S.; Klementeva, T.N.; Yaroslavtseva, O.N.; Khodyrev, V.P.; Kruykova, N.A.; Glupov, V.V. Citrobacter freundii, a natural associate of the Colorado potato beetle, increases larval susceptibility to Bacillus thuringiensis. Pest. Manag. Sci. 2022. [Google Scholar] [CrossRef]
- Favia, G.; Ricci, I.; Damiani, C.; Raddadi, N.; Crotti, E.; Marzorati, M.; Rizzi, A.; Urso, R.; Brusetti, L.; Borin, S.; et al. Bacteria of the genus Asaia stably associate with Anopheles stephensi, an Asian malarial mosquito vector. Proc. Natl. Acad. Sci. USA 2007, 104, 9047–9051. [Google Scholar] [CrossRef] [Green Version]
- Cappelli, A.; Damiani, C.; Mancini, M.V.; Valzano, M.; Rossi, P.; Serrao, A.; Ricci, I.; Favia, G. Asaia Activates Immune Genes in Mosquito Eliciting an Anti-Plasmodium Response: Implications in Malaria Control. Front. Genet. 2019, 10, 836. [Google Scholar] [CrossRef] [Green Version]
- Behar, A.; Yuval, B.; Jurkevitch, E. Gut bacterial communities in the Mediterranean fruit fly (Ceratitis capitata) and their impact on host longevity. J. Insect Physiol. 2008, 54, 1377–1383. [Google Scholar] [CrossRef]
- Aharon, Y.; Pasternak, Z.; Ben Yosef, M.; Behar, A.; Lauzon, C.; Yuval, B.; Jurkevitch, E. Phylogenetic, metabolic, and taxonomic diversities shape mediterranean fruit fly microbiotas during ontogeny. Appl. Environ. Microbiol. 2013, 79, 303–313. [Google Scholar] [CrossRef] [Green Version]
- Malacrinò, A.; Campolo, O.; Medina, R.F.; Palmeri, V. Instar- and host-associated differentiation of bacterial communities in the Mediterranean fruit fly Ceratitis capitata. PLoS ONE 2018, 13, e0194131. [Google Scholar] [CrossRef] [PubMed]
- Zaada, D.S.Y.; Ben-Yosef, M.; Yuval, B.; Jurkevitch, E. The host fruit amplifies mutualistic interaction between Ceratitis capitata larvae and associated bacteria. BMC Biotechnol. 2019, 19, 92. [Google Scholar] [CrossRef] [PubMed] [Green Version]
- Nikolouli, K.; Augustinos, A.A.; Stathopoulou, P.; Asimakis, E.; Mintzas, A.; Bourtzis, K.; Tsiamis, G. Genetic structure and symbiotic profile of worldwide natural populations of the Mediterranean fruit fly, Ceratitis capitata. BMC Genet. 2020, 21, 128. [Google Scholar] [CrossRef] [PubMed]
- Ben Ami, E.; Yuval, B.; Jurkevitch, E. Manipulation of the microbiota of mass-reared Mediterranean fruit flies Ceratitis capitata (Diptera: Tephritidae) improves sterile male sexual performance. ISME J. 2010, 4, 28–37. [Google Scholar] [CrossRef] [PubMed]
- Zabalou, S.; Apostolaki, A.; Livadaras, I.; Franz, G.; Robinson, A.S.; Savakis, C.; Bourtzis, K. Incompatible insect technique: Incompatible males from a Ceratitis capitata genetic sexing strain. Entomol. Exp. Appl. 2009, 132, 232–240. [Google Scholar] [CrossRef]
- Kyritsis, G.A.; Augustinos, A.A.; Livadaras, I.; Cáceres, C.; Bourtzis, K.; Papadopoulos, N.T. Medfly-Wolbachia symbiosis: Genotype x genotype interactions determine host’s life history traits under mass rearing conditions. BMC Biotechnol. 2019, 19, 96. [Google Scholar] [CrossRef] [Green Version]
- Kyritsis, G.A.; Augustinos, A.A.; Cáceres, C.; Bourtzis, K. Medfly Gut Microbiota and Enhancement of the Sterile Insect Technique: Similarities and Differences of Klebsiella oxytoca and Enterobacter sp. AA26 Probiotics during the Larval and Adult Stages of the VIENNA 8 D53+ Genetic Sexing Strain. Front. Microbiol. 2017, 8, 2064. [Google Scholar] [CrossRef]
- Cai, Z.; Yao, Z.; Li, Y.; Xi, Z.; Bourtzis, K.; Zhao, Z.; Bai, S.; Zhang, H. Intestinal probiotics restore the ecological fitness decline of. Evol. Appl. 2018, 11, 1946–1963. [Google Scholar] [CrossRef]
- Cheng, D.; Guo, Z.; Riegler, M.; Xi, Z.; Liang, G.; Xu, Y. Gut symbiont enhances insecticide resistance in a significant pest, the oriental fruit fly Bactrocera dorsalis (Hendel). Microbiome 2017, 5, 13. [Google Scholar] [CrossRef] [Green Version]
- Wang, H.; Jin, L.; Zhang, H. Comparison of the diversity of the bacterial communities in the intestinal tract of adult Bactrocera dorsalis from three different populations. J. Appl. Microbiol. 2011, 110, 1390–1401. [Google Scholar] [CrossRef]
- Muniz, L.R.; Knosp, C.; Yeretssian, G. Intestinal antimicrobial peptides during homeostasis, infection, and disease. Front. Immunol. 2012, 3, 310. [Google Scholar] [CrossRef] [PubMed] [Green Version]
- Raza, M.F.; Wang, Y.; Cai, Z.; Bai, S.; Yao, Z.; Awan, U.A.; Zhang, Z.; Zheng, W.; Zhang, H. Gut microbiota promotes host resistance to low-temperature stress by stimulating its arginine and proline metabolism pathway in adult Bactrocera dorsalis. PLoS Pathog. 2020, 16, e1008441. [Google Scholar] [CrossRef] [PubMed] [Green Version]
- Saul, S. Rearing methods for the medfly, Ceratitis capitata. Ann. Entomol. Soc. Am. 1982, 75, 480–483. [Google Scholar] [CrossRef]
- Klindworth, A.; Pruesse, E.; Schweer, T.; Peplies, J.; Quast, C.; Horn, M.; Glöckner, F.O. Evaluation of general 16S ribosomal RNA gene PCR primers for classical and next-generation sequencing-based diversity studies. Nucleic Acids Res. 2013, 41, e1. [Google Scholar] [CrossRef]
- Schloss, P.D.; Westcott, S.L.; Ryabin, T.; Hall, J.R.; Hartmann, M.; Hollister, E.B.; Lesniewski, R.A.; Oakley, B.B.; Parks, D.H.; Robinson, C.J.; et al. Introducing mothur: Open-source, platform-independent, community-supported software for describing and comparing microbial communities. Appl. Environ. Microbiol. 2009, 75, 7537–7541. [Google Scholar] [CrossRef] [Green Version]
- Caporaso, J.G.; Kuczynski, J.; Stombaugh, J.; Bittinger, K.; Bushman, F.D.; Costello, E.K.; Fierer, N.; Peña, A.G.; Goodrich, J.K.; Gordon, J.I.; et al. QIIME allows analysis of high-throughput community sequencing data. Nat. Methods 2010, 7, 335–336. [Google Scholar] [CrossRef] [Green Version]
- Altschul, S.F.; Gish, W.; Miller, W.; Myers, E.W.; Lipman, D.J. Basic local alignment search tool. J. Mol. Biol. 1990, 215, 403–410. [Google Scholar] [CrossRef]
- Ciolfi, S.; Marri, L. Dominant symbiotic bacteria associated with wild medfly populations reveal a bacteriocin-like killing phenotype: A ‘cold-case’ study. Bull. Entomol. Res. 2020, 110, 457–462. [Google Scholar] [CrossRef]
- Zabalou, S.; Riegler, M.; Theodorakopoulou, M.; Stauffer, C.; Savakis, C.; Bourtzis, K. Wolbachia-induced cytoplasmic incompatibility as a means for insect pest population control. Proc. Natl. Acad. Sci. USA 2004, 101, 15042–15045. [Google Scholar] [CrossRef] [Green Version]
- Itoh, H.; Jang, S.; Takeshita, K.; Ohbayashi, T.; Ohnishi, N.; Meng, X.Y.; Mitani, Y.; Kikuchi, Y. Host-symbiont specificity determined by microbe-microbe competition in an insect gut. Proc. Natl. Acad. Sci. USA 2019, 116, 22673–22682. [Google Scholar] [CrossRef]
- Shukla, S.P.; Vogel, H.; Heckel, D.G.; Vilcinskas, A.; Kaltenpoth, M. Burying beetles regulate the microbiome of carcasses and use it to transmit a core microbiota to their offspring. Mol. Ecol. 2018, 27, 1980–1991. [Google Scholar] [CrossRef] [PubMed]
- Jurkevitch, E. Riding the Trojan horse: Combating pest insects with their own symbionts. Microb. Biotechnol. 2011, 4, 620–627. [Google Scholar] [CrossRef] [PubMed] [Green Version]
- De Cock, M.; Virgilio, M.; Vandamme, P.; Augustinos, A.; Bourtzis, K.; Willems, A.; De Meyer, M. Impact of Sample Preservation and Manipulation on Insect Gut Microbiome Profiling. A Test Case with Fruit Flies (Diptera, Tephritidae). Front. Microbiol. 2019, 10, 2833. [Google Scholar] [CrossRef] [PubMed] [Green Version]
- De Cock, M.; Virgilio, M.; Vandamme, P.; Bourtzis, K.; De Meyer, M.; Willems, A. Comparative Microbiomics of Tephritid Frugivorous Pests (Diptera: Tephritidae) From the Field: A Tale of High Variability Across and Within Species. Front. Microbiol. 2020, 11, 1890. [Google Scholar] [CrossRef] [PubMed]
- Muturi, E.J.; Ramirez, J.L.; Rooney, A.P.; Kim, C.H. Comparative analysis of gut microbiota of mosquito communities in central Illinois. PLoS Negl. Trop. Dis. 2017, 11, e0005377. [Google Scholar] [CrossRef]
- Akami, M.; Ren, X.M.; Qi, X.; Mansour, A.; Gao, B.; Cao, S.; Niu, C.Y. Symbiotic bacteria motivate the foraging decision and promote fecundity and survival of Bactrocera dorsalis (Diptera: Tephritidae). BMC Microbiol. 2019, 19, 229. [Google Scholar] [CrossRef] [Green Version]
- Behar, A.; Yuval, B.; Jurkevitch, E. Enterobacteria-mediated nitrogen fixation in natural populations of the fruit fly Ceratitis capitata. Mol. Ecol. 2005, 14, 2637–2643. [Google Scholar] [CrossRef]
- Behar, A.; Yuval, B.; Jurkevitch, E. Community Structure of the Mediterranean Fruit Fly Microbiota: Seasonal and Spatial Sources of Variation. Isr. J. Ecol. Evol. 2008, 54, 181–191. [Google Scholar] [CrossRef]
- Ben-Yosef, M.; Jurkevitch, E.; Yuval, B. Effect of bacteria on nutritional status and reproductive success of the Mediterranean fruit fly Ceratitis capitata. Physiol. Entomol. 2008, 33, 145–154. [Google Scholar] [CrossRef]
- Hughes, G.L.; Dodson, B.L.; Johnson, R.M.; Murdock, C.C.; Tsujimoto, H.; Suzuki, Y.; Patt, A.A.; Cui, L.; Nossa, C.W.; Barry, R.M.; et al. Native microbiome impedes vertical transmission of Wolbachia in Anopheles mosquitoes. Proc. Natl. Acad. Sci. USA 2014, 111, 12498–12503. [Google Scholar] [CrossRef] [Green Version]
- Rossi, P.; Ricci, I.; Cappelli, A.; Damiani, C.; Ulissi, U.; Mancini, M.V.; Valzano, M.; Capone, A.; Epis, S.; Crotti, E.; et al. Mutual exclusion of Asaia and Wolbachia in the reproductive organs of mosquito vectors. Parasites Vectors 2015, 8, 278. [Google Scholar] [CrossRef] [PubMed]

Publisher’s Note: MDPI stays neutral with regard to jurisdictional claims in published maps and institutional affiliations. |
© 2022 by the authors. Licensee MDPI, Basel, Switzerland. This article is an open access article distributed under the terms and conditions of the Creative Commons Attribution (CC BY) license (https://creativecommons.org/licenses/by/4.0/).
Share and Cite
Cappelli, A.; Petrelli, D.; Gasperi, G.; Serrao, A.G.M.; Ricci, I.; Damiani, C.; Favia, G. Bacterial Symbionts in Ceratitis capitata. Insects 2022, 13, 474. https://doi.org/10.3390/insects13050474
Cappelli A, Petrelli D, Gasperi G, Serrao AGM, Ricci I, Damiani C, Favia G. Bacterial Symbionts in Ceratitis capitata. Insects. 2022; 13(5):474. https://doi.org/10.3390/insects13050474
Chicago/Turabian StyleCappelli, Alessia, Dezemona Petrelli, Giuliano Gasperi, Aurelio Giuseppe Maria Serrao, Irene Ricci, Claudia Damiani, and Guido Favia. 2022. "Bacterial Symbionts in Ceratitis capitata" Insects 13, no. 5: 474. https://doi.org/10.3390/insects13050474
APA StyleCappelli, A., Petrelli, D., Gasperi, G., Serrao, A. G. M., Ricci, I., Damiani, C., & Favia, G. (2022). Bacterial Symbionts in Ceratitis capitata. Insects, 13(5), 474. https://doi.org/10.3390/insects13050474

